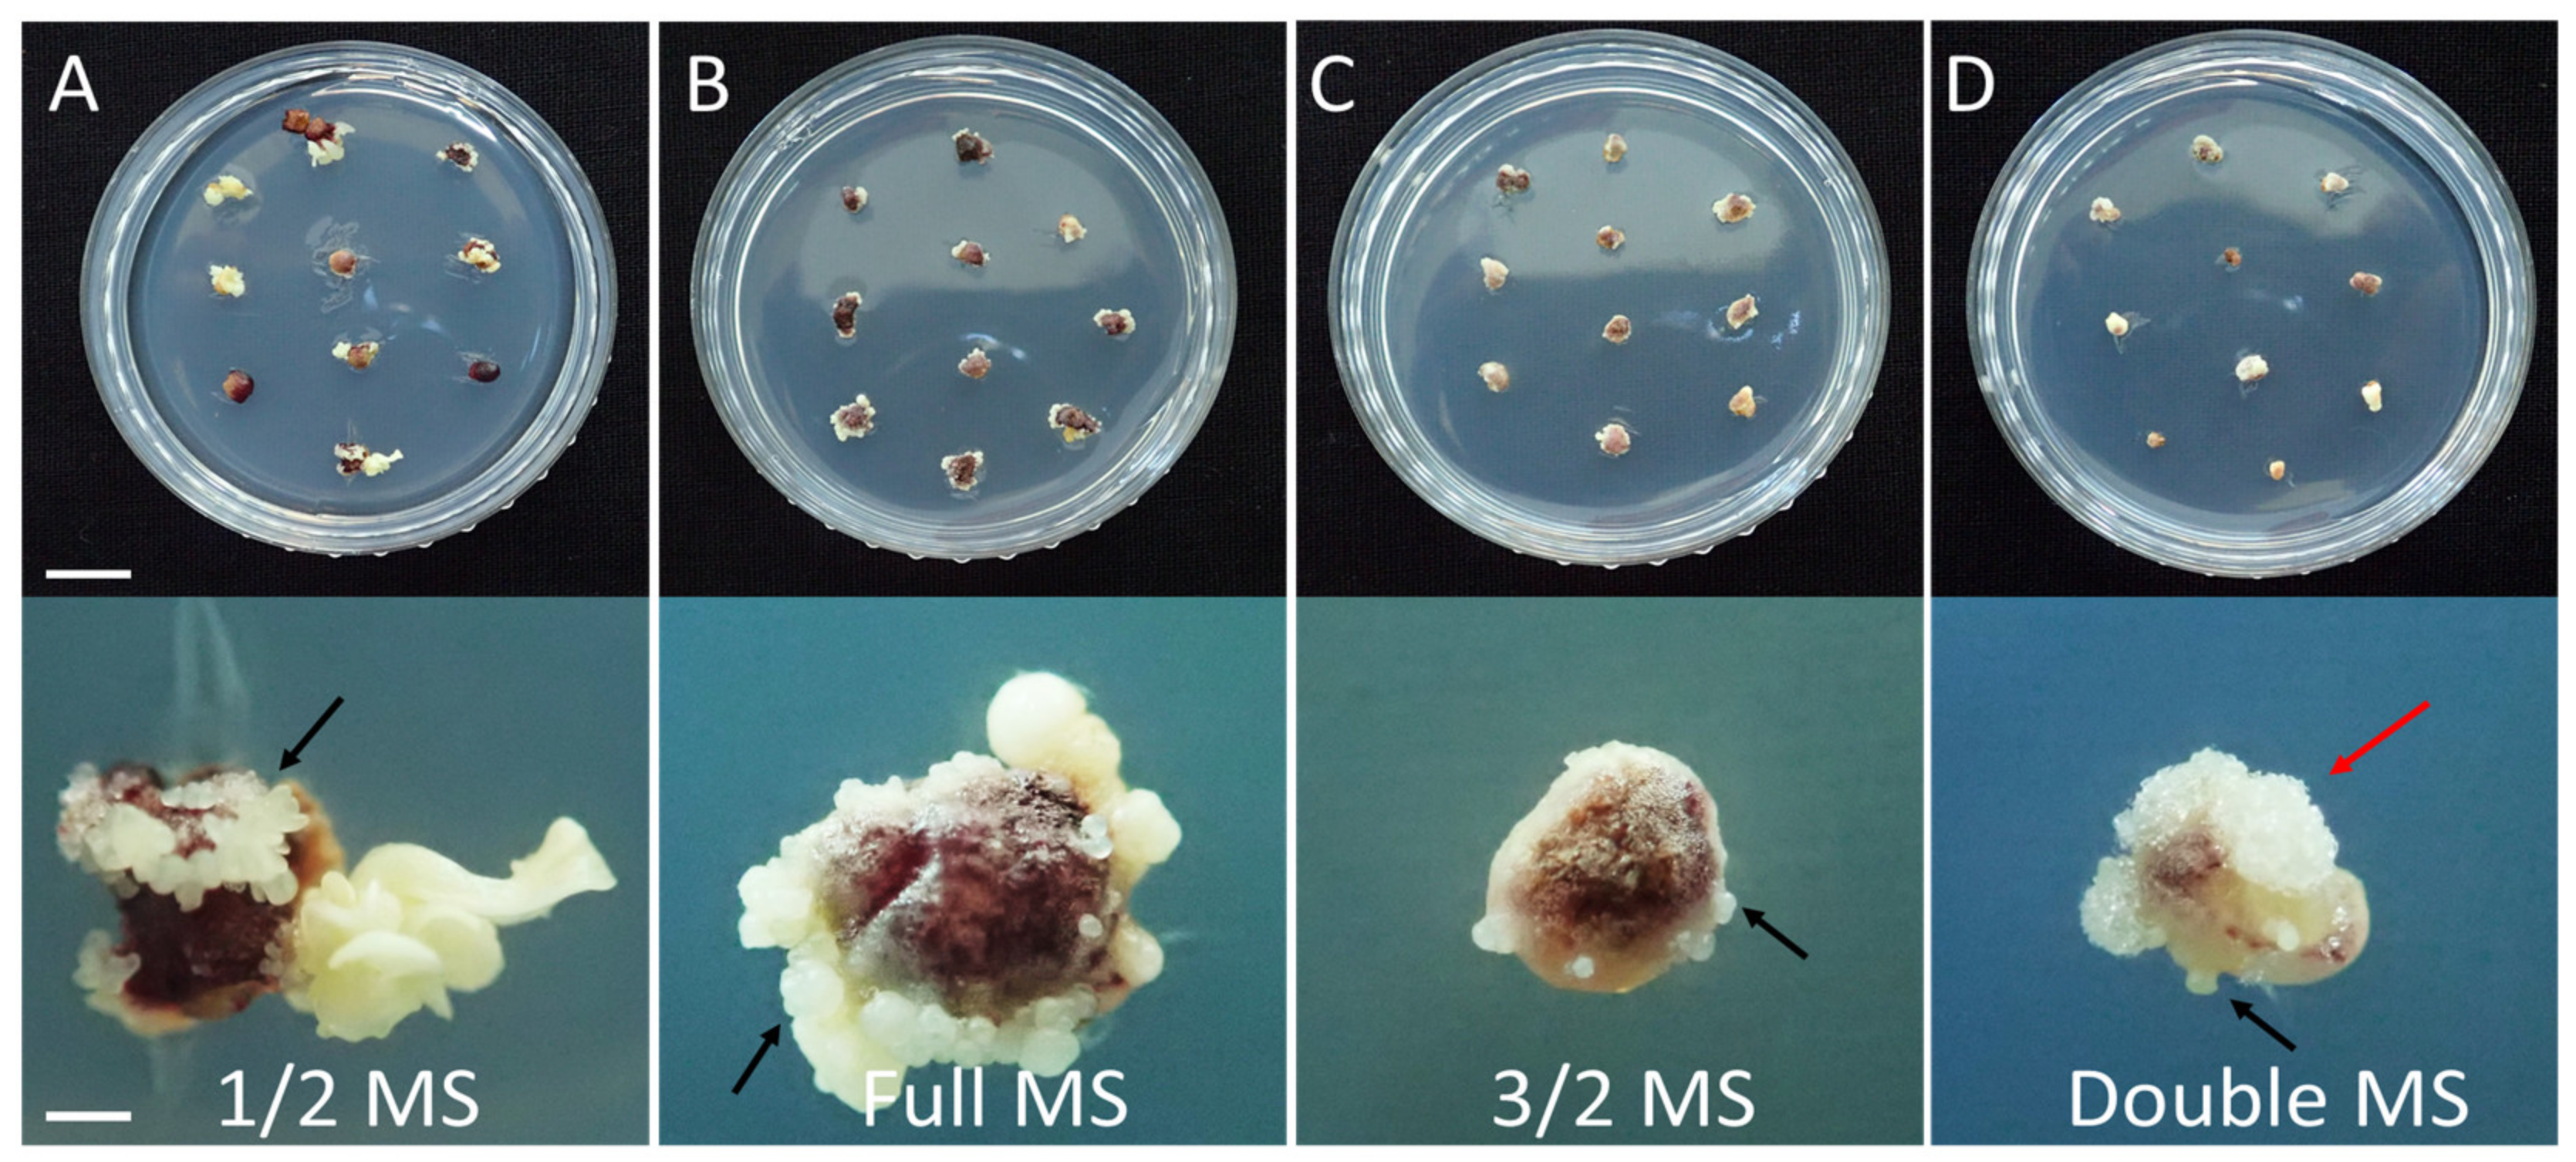
Plants 12 01270 g003

Efficient Somatic Embryogenesis, Regeneration and Acclimatization of Panax ginseng Meyer: True-to-Type Conformity of Plantlets as Confirmed by ISSR Analysis
Abstract
1. Introduction
2. Results
2.1. Somatic Embryogenesis
2.2. Plant Regeneration
2.3. Acclimatization
2.4. Genetic Fidelity
3. Discussion
4. Materials and Methods
4.1. Somatic Embryogenesis
4.2. Plant Regeneration
4.3. Acclimatization
4.4. Growth Condition
4.5. Genetic Fidelity Analysis
4.6. Data Analysis
5. Conclusions
Supplementary Materials
Author Contributions
Funding
Data Availability Statement
Conflicts of Interest
References
- Yang, W.Z.; Hu, Y.; Wu, W.Y.; Ye, M.; Guo, D.A. Saponins in the genus Panax L. (Araliaceae): A systematic review of their chemical diversity. Phytochem 2014, 106, 7–24. [Google Scholar] [CrossRef] [PubMed]
- Ratan, Z.A.; Haidere, M.F.; Hong, Y.H.; Park, S.H.; Lee, J.O.; Lee, J.; Cho, J.Y. Pharmacological potential of ginseng and its major component ginsenosides. J. Ginseng Res. 2020, 45, 199–210. [Google Scholar] [CrossRef] [PubMed]
- Kim, Y.J.; Lee, O.R.; Kim, K.T.; Yang, D.C. High frequency of plant regeneration through cyclic secondary somatic embryogenesis in Panax ginseng. J. Ginseng Res. 2012, 36, 442–448. [Google Scholar] [CrossRef] [PubMed]
- Lee, J.W.; Jo, I.H.; Kim, J.U.; Hong, C.E.; Kim, Y.C.; Kim, D.H.; Park, Y.D. Improvement of seed dehiscence and germination in ginseng by stratification, gibberellin, and/or kinetin treatments. Hortic. Environ. Biotechnol. 2018, 59, 293–301. [Google Scholar] [CrossRef]
- Bang, K.W.; Kim, Y.C.; Lee, J.W.; Jo, I.H.; Hong, C.E.; Hyun, D.Y.; Kim, J.U. Major achievement and prospect of ginseng breeding in Korea. Korean J. Breed. Sci. 2020, 52, 170–178. [Google Scholar] [CrossRef]
- Ko, S.M.; Lee, J.H.; Oh, M.M. Control of relative humidity and root-zone water content for acclimation of in vitro-propagated M9 apple rootstock plantlets. Hortic. Environ. Biotechnol. 2018, 59, 303–313. [Google Scholar] [CrossRef]
- Guan, Y.; Li, S.G.; Fan, X.F.; Su, Z.H. Application of somatic embryogenesis in woody plants. Front. Plant Sci. 2016, 7, 938. [Google Scholar] [CrossRef]
- Kumar, V.; Moyo, M.; Van Staden, J. Somatic embryogenesis of Pelargonium sidoides DC. Plant Cell Tissue Organ Cult. 2015, 121, 571–577. [Google Scholar] [CrossRef]
- Isah, T.; Umar, S. Influencing in vitro clonal propagation of Chonemorpha fragrans (moon) Alston by culture media strength, plant growth regulators, carbon source and photo periodic incubation. J. For. Res. 2020, 31, 27–43. [Google Scholar] [CrossRef]
- Phillips, G.C.; Garda, M. Plant tissue culture media and practices: An overview. In Vitro Cell. Dev. Biol. Plant 2019, 55, 242–257. [Google Scholar] [CrossRef]
- Kim, O.T.; Kim, T.S.; Bang, K.H.; In, D.S.; Kim, Y.C.; Choi, Y.E.; Cha, S.W.; Seong, N.S. Optimization of direct somatic embryogenesis from mature zygotic embryos of Panax ginseng C. A. Meyer. J. Plant Biol. 2006, 49, 348–352. [Google Scholar] [CrossRef]
- Lee, J.W.; Jo, I.H.; Kim, J.U.; Hong, C.E.; Bang, K.H.; Park, Y.D. Determination of mutagenic sensitivity to gamma rays in ginseng (Panax ginseng) dehiscent seeds, roots, and somatic embryos. Hortic. Environ. Biotechnol. 2019, 60, 721–731. [Google Scholar] [CrossRef]
- Zhang, J.Y.; Sun, H.J.; Song, I.J.; Bae, T.W.; Kang, H.G.; Ko, S.M.; Kwon, Y.I.; Kim, I.W.; Lee, J.C.; Park, S.Y.; et al. Plant regeneration of Korean wild ginseng (Panax ginseng Meyer) mutant lines induced by γ-irradiation (60Co) of adventitious roots. J. Ginseng Res. 2014, 38, 220–225. [Google Scholar] [CrossRef] [PubMed]
- Kim, J.Y.; Adhikari, P.B.; Ahn, C.H.; Kim, D.H.; Kim, Y.C.; Han, J.Y.; Kondeti, S.; Choi, Y.E. High frequency somatic embryogenesis and plant regeneration of interspecific ginseng hybrid between Panax ginseng and Panax quinquefolius. J. Ginseng Res. 2019, 43, 38–48. [Google Scholar] [CrossRef]
- Arano-Avalosa, S.; Gómez-Merinoa, F.C.; Mancilla-Álvarezb, E.; Sánchez-Páeza, R.; Bello-Belloc, J.J. An efficient protocol for commercial micropropagation of malanga (Colocasia esculenta L. Schott) using temporary immersion. Sci. Hortic. 2020, 261, 108998. [Google Scholar] [CrossRef]
- Choi, Y.E.; Yang, D.C.; Yoon, E.S.; Choi, K.T. Plant regeneration via adventitious bud formation from cotyledon explants of Panax ginseng C. A. Meyer. Plant Cell Rep. 1998, 17, 731–736. [Google Scholar] [CrossRef]
- Chen, A.H.; Yang, J.L.; Niu, Y.D.; Yang, C.P.; Liu, G.F.; Yu, C.Y.; Li, C.H. High-frequency somatic embryogenesis from germinated zygotic embryos of Schisandra chinensis and evaluation of the effects of medium strength, sucrose, GA3, and BA on somatic embryo development. Plant Cell Tissue Organ Cult. 2020, 102, 357–364. [Google Scholar] [CrossRef]
- Pinto, G.; Silva, S.; Park, Y.S.; Neves, L.; Araujo, C.; Santos, C. Factors influencing somatic embryogenesis induction in Eucalyptus globulus Labill.: Basal medium and anti-browning agents. In Vitro Cell. Dev. Biol. Plant 2008, 38, 116–124. [Google Scholar] [CrossRef]
- Raomai, S.; Kumaria, S.; Tandon, P. Plant regeneration through direct somatic embryogenesis from immature zygotic embryos of the medicinal plant, Paris polyphylla Sm. Plant Cell Tissue Organ Cult. 2014, 118, 445–455. [Google Scholar] [CrossRef]
- Adil, M.; Jeong, B.R. In vitro cultivation of Panax ginseng C.A. Meyer. Ind. Crops Prod. 2018, 122, 239–251. [Google Scholar] [CrossRef]
- Fuentes-Cerda, C.F.J.; Monforte-Gonzalez, M.; Mendez-Zeel, M.; Rojas-Herrera, R.; Loyola-Vargas, V.M. Modification of the embryogenic response of Coffea arabica by the nitrogen source. Biotechnol. Lett. 2001, 23, 1341–1343. [Google Scholar] [CrossRef]
- Nuutila, A.M.; Kurthn, U.; Kauppinen, V. Optimization of sucrose and inorganic nitrogen concentrations for somatic embryogenesis of birch (Betula pendula Roth.) callus cultures: A statistical approach. Plant Cell Tissue Organ Cult. 1991, 24, 73–77. [Google Scholar] [CrossRef]
- Duarte-Aké, F.; Márquez-López, R.E.; Monroy-González, Z.; Borbolla-Pérez, V.; Loyola-Vargas, V.M. The source, level, and balance of nitrogen during the somatic embryogenesis process drive cellular differentiation. Planta 2022, 256, 113. [Google Scholar] [CrossRef] [PubMed]
- Choi, Y.E.; Sho, W.Y. Effect of ammonium ion on morphogenesis from cultured cotyledon explants of Panax ginseng. J. Plant Biol. 1997, 40, 21–26. [Google Scholar]
- Meijer, E.G.M.; Brown, D.C.W. Role of exogenous reduced nitrogen and sucrose in rapid high frequency somatic embryogenesis in Medicago sativa. Plant Cell Tissue Organ Cult. 1987, 10, 11–19. [Google Scholar] [CrossRef]
- Ramage, C.M.; Williams, R.R. Mineral nutrition and plant morphogenesis. In Vitro Cell. Dev. Biol. Plant 2002, 38, 116–124. [Google Scholar] [CrossRef]
- Menke-Milczarek, Z.; Zimny, J. NH4+ and NO3 requirement for wheat somatic embryogenesis. Acta Physiol. Plant 2001, 23, 37–42. [Google Scholar] [CrossRef]
- Dal Vesco, L.L.; Guerra, M.P. The effectiveness of nitrogen sources in Feijoa somatic embryogenesis. Plant Cell Tissue Organ Cult. 2001, 64, 19–25. [Google Scholar] [CrossRef]
- Hilae, A.; Te-chato, S. Effects of carbon sources and strength of MS medium on germination of somatic embryos of oil palm (Elaeis quineensis Jacq). J. Sci. Technol. 2005, 27, 629–635. [Google Scholar]
- Choi, Y.E.; Yang, D.C.; Choi, K.T. Induction of somatic embryos by macrosalt stress from mature zygotic embryos of Panax ginseng. Plant Cell Tissue Organ Cult. 1998, 52, 177–181. [Google Scholar] [CrossRef]
- Liao, Y.K.; Amerson, H.V. Slash pine (Pinus elliottii Engelm.) somatic embryogenesis II. Maturation of somatic embryos and plant regeneration. New For. 1995, 10, 165–182. [Google Scholar] [CrossRef]
- Prakash, M.G.; Gurumurthi, K. Effects of type of explant and age, plant growth regulators and medium strength on somatic embryogenesis and plant regeneration in Eucalyptus camaldulensis. Plant Cell Tissue Organ Cult. 2010, 100, 13–20. [Google Scholar] [CrossRef]
- Carlsson, J.; Egertsdotter, U.; Ganeteg, U.; Svennerstam, H. Nitrogen utilization during germination of somatic embryos of Norway spruce: Revealing the importance of supplied glutamine for nitrogen metabolism. Trees 2019, 33, 383–394. [Google Scholar] [CrossRef]
- Choi, Y.E.; Yang, D.C.; Yoon, E.S.; Choi, K.T. High-efficiency plant production via direct somatic single embryogenesis from preplasmolysed cotyledons of Panax ginseng and possible dormancy of somatic embryos. Plant Cell Rep. 1999, 18, 493–499. [Google Scholar] [CrossRef]
- Lee, J.W.; Do, G.R.; Jo, I.H.; Hong, C.E.; Bang, K.H.; Kim, J.U.; Park, Y.D. Zygotic embryo culture is an efficient way to optimize in vitro growth in Panax ginseng. Ind. Crops Prod. 2021, 167, 1134971. [Google Scholar] [CrossRef]
- Kim, J.Y.; Kim, D.H.; Kim, Y.C.; Kim, K.H.; Han, J.Y.; Choi, Y.E. In vitro grown thickened taproots, a new type of soil transplanting source in Panax ginseng. J. Ginseng Res. 2016, 40, 409–414. [Google Scholar] [CrossRef]
- Cakmak, I.; Yazici, A.M. Magnesium: A forgotten element in crop production. Better Crops 2010, 94, 23–25. [Google Scholar]
- Rehman, H.U.; Alharby, H.F.; Alzahrani, Y.; Rady, M.M. Magnesium and organic biostimulant integrative application induces physiological and biochemical changes in sunflower plants and its harvested progeny on sandy soil. Plant Physiol. Biochem. 2018, 126, 97–105. [Google Scholar] [CrossRef]
- Xiao, J.X.; Hu, C.Y.; Chen, Y.Y.; Yang, B.; Hua, J. Effects of low magnesium and an arbuscular mycorrhizal fungus on the growth, magnesium distribution and photosynthesis of two citrus cultivars. Sci. Hortic. 2014, 177, 14–20. [Google Scholar] [CrossRef]
- Hauer-Jákli, M.; Tränkner, M. Critical leaf magnesium thresholds and the impact of magnesium on plant growth and photo-oxidative defense: A systematic review and meta-analysis from 70 years of research. Front. Plant Sci. 2019, 10, 766. [Google Scholar] [CrossRef]
- Kim, Y.C.; Park, H.W.; Kim, O.T.; Bang, K.H.; Kim, J.U.; Hyun, D.Y.; Kim, D.H.; Cha, S.W.; Choi, J.E. Soil acclimatization of regenerated plants by gibberellic acid treatments of Panax ginseng C. A. Meyer. Korean J. Plant Res. 2013, 26, 84–89. [Google Scholar] [CrossRef]
- Konar, S.; Karmakar, J.; Ray, A.; Adhikari, S.; Bandyopadhyay, T.K. Regeneration of plantlets through somatic embryogenesis from root derived calli of Hibiscus sabdariffa L. (Roselle) and assessment of genetic stability by flow cytometry and ISSR analysis. PLoS ONE 2018, 13, e0202324. [Google Scholar] [CrossRef] [PubMed]
- Gamborg, O.L.; Miller, R.A.; Ojima, K. Nutrient requirements of suspension culture of soybean root cells. Exp. Cell Res. 1968, 50, 151–158. [Google Scholar] [CrossRef]
- Gresshoff, P.M.; Doy, C.H. Development and differentiation of haploid Lycopersicon esculentum (tomato). Planta 1972, 107, 161–170. [Google Scholar] [CrossRef]
- Murashige, T.; Skoog, F. A revised medium for rapid growth and bioassays with tobacco tissue cultures. Physiol. Plant. 1962, 15, 473–497. [Google Scholar] [CrossRef]
- Chu, C.C. The N6 medium and its applications to anther culture of cereal crops. In Proceedings of the Symposium on Plant Tissue Culture, Beijing, China, 25–30 May 1978. [Google Scholar]
- Schenk, R.U.; Hildebrandt, A.C. Medium and techniques for induction and growth of monocotyledonous and dicotyledonous plant cell cultures. Can. J. Bot. 1972, 50, 199–204. [Google Scholar] [CrossRef]
- Lee, J.W.; Kim, Y.C.; Jo, I.H.; Seo, A.Y.; Lee, J.H.; Kim, O.T.; Hyun, D.Y.; Cha, S.W.; Bang, K.H.; Cho, J.H. Development of an ISSR-derived SCAR marker in Korean ginseng cultivars (Panax ginseng C. A. Meyer). J. Ginseng Res. 2011, 35, 52–59. [Google Scholar] [CrossRef]

| IGR Weight (g) | Sprouting Rate (%) | Stem Length (cm) | Stem Diameter (mm) | Leaf Length (cm) | Leaf Width (cm) |
|---|---|---|---|---|---|
| 0.15 | 75.0 ± 8.7 b | 4.3 ± 0.3 b | 0.88 ± 0.04 c | 3.0 ± 0.2 d | 1.6 ± 0.2 d |
| 0.30 | 91.7 ± 2.9 a | 4.7 ± 0.5 b | 0.93 ± 0.03 c | 3.5 ± 0.4 c | 2.0 ± 0.2 c |
| 0.45 | 96.7 ± 5.8 a | 5.7 ± 0.4 a | 1.03 ± 0.03 b | 4.1 ± 0.2 b | 2.2 ± 0.1 b |
| 0.60 | 96.7 ± 2.9 a | 6.3 ± 0.7 a | 1.18 ± 0.08 a | 4.7 ± 0.2 a | 2.6 ± 0.1 a |
| IGR Weight (g) | Survival Rate (%) | Root Weight (g) | Root Diameter (mm) | Root Length (cm) |
|---|---|---|---|---|
| 0.15 | 57.5 ± 15.5 b | 0.5 ± 0.0 d | 5.28 ± 0.50 c | 12.8 ± 0.6 b |
| 0.30 | 70.0 ± 10.8 ab | 0.8 ± 0.2 c | 6.45 ± 0.31 b | 14.7 ± 1.6 b |
| 0.45 | 76.3 ± 8.5 a | 1.5 ± 0.1 b | 7.80 ± 0.55 a | 16.8 ± 1.1 a |
| 0.60 | 86.3 ± 7.5 a | 1.8 ± 0.2 a | 8.05 ± 0.57 a | 17.8 ± 1.6 a |
| Basal Medium Type | |||||
|---|---|---|---|---|---|
| Macro-Element Ions (mM) | B5 | GD | MS | N6 | SH |
| NH4+ | 2.02 | 12.49 | 20.61 | 7.00 | 2.61 |
| NO3− | 24.73 | 24.46 | 39.40 | 27.99 | 24.73 |
| H2PO4− | 1.09 | 2.2 | 1.25 | 2.94 | 2.61 |
| K+ | 24.73 | 12.96 | 20.04 | 30.93 | 24.73 |
| Ca2+ | 1.02 | 1.04 | 2.99 | 1.13 | 1.36 |
| Na+ | 1.19 | 0.10 | 0.10 | 0.10 | 0.05 |
| SO42− | 2.09 | 0.15 | 1.54 | 4.27 | 1.62 |
| Cl− | 2.04 | 0.87 | 5.98 | 2.26 | 2.72 |
| Mg2+ | 1.01 | 0.14 | 1.5 | 0.75 | 1.62 |
| Total nitrogen | 26.75 | 36.95 | 60.01 | 34.99 | 27.34 |
| NH4+:NO3− | 1:12 | 1:2 | 1:2 | 1:4 | 1:12 |
Disclaimer/Publisher’s Note: The statements, opinions and data contained in all publications are solely those of the individual author(s) and contributor(s) and not of MDPI and/or the editor(s). MDPI and/or the editor(s) disclaim responsibility for any injury to people or property resulting from any ideas, methods, instructions or products referred to in the content. |
© 2023 by the authors. Licensee MDPI, Basel, Switzerland. This article is an open access article distributed under the terms and conditions of the Creative Commons Attribution (CC BY) license (https://creativecommons.org/licenses/by/4.0/).
Share and Cite
Lee, J.-W.; Kim, J.-U.; Bang, K.-H.; Kwon, N.; Kim, Y.-C.; Jo, I.-H.; Park, Y.-D. Efficient Somatic Embryogenesis, Regeneration and Acclimatization of Panax ginseng Meyer: True-to-Type Conformity of Plantlets as Confirmed by ISSR Analysis. Plants 2023, 12, 1270. https://doi.org/10.3390/plants12061270
Lee J-W, Kim J-U, Bang K-H, Kwon N, Kim Y-C, Jo I-H, Park Y-D. Efficient Somatic Embryogenesis, Regeneration and Acclimatization of Panax ginseng Meyer: True-to-Type Conformity of Plantlets as Confirmed by ISSR Analysis. Plants. 2023; 12(6):1270. https://doi.org/10.3390/plants12061270
Chicago/Turabian StyleLee, Jung-Woo, Jang-Uk Kim, Kyong-Hwan Bang, Nayeong Kwon, Young-Chang Kim, Ick-Hyun Jo, and Young-Doo Park. 2023. "Efficient Somatic Embryogenesis, Regeneration and Acclimatization of Panax ginseng Meyer: True-to-Type Conformity of Plantlets as Confirmed by ISSR Analysis" Plants 12, no. 6: 1270. https://doi.org/10.3390/plants12061270
APA StyleLee, J.-W., Kim, J.-U., Bang, K.-H., Kwon, N., Kim, Y.-C., Jo, I.-H., & Park, Y.-D. (2023). Efficient Somatic Embryogenesis, Regeneration and Acclimatization of Panax ginseng Meyer: True-to-Type Conformity of Plantlets as Confirmed by ISSR Analysis. Plants, 12(6), 1270. https://doi.org/10.3390/plants12061270

